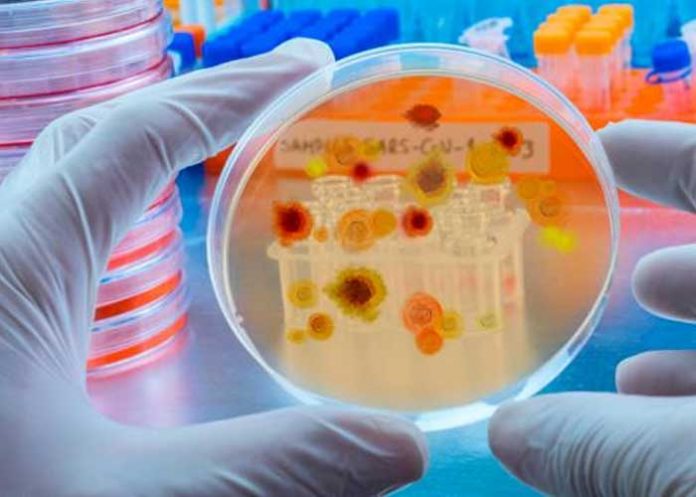
La OMS publica la lista de hongos que amenazan la salud

La primera lista de los 19 ‘patógenos prioritarios‘, han sido publicados por La Organización Mundial de la Salud (OMS). A su vez, los expertos lo identificaron como la «mayor amenaza para la salud pública»; advirtiendo que algunas cepas son cada vez más resistentes a los medicamentos y se están extendiendo.
«Los hongos son la enfermedad infecciosa ‘olvidada’. Causan enfermedades devastadoras, pero se han descuidado durante tanto tiempo que apenas comprendemos la dimensión del problema»; dijo en un comunicado Justin Beardsley del Instituto de Enfermedades Infecciosas de la Universidad de Sídney, que dirigió el grupo de estudio.
Según el informe, «las infecciones bacterianas farmacorresistentes causan directamente 1,27 millones de muertes y contribuyen a unos 4,95 millones de muertes al año».
Asimismo, señala que «la incidencia y el rango geográfico de las enfermedades fúngicas se están expandiendo en todo el mundo debido al calentamiento global y al aumento de los viajes y el comercio internacional». Además, destaca que durante la pandemia del covid-19, la incidencia de al menos tres infecciones fúngicas mortales aumentó significativamente entre los pacientes hospitalizados.
La OMS publica la lista de hongos que amenazan la salud

La agencia internacional de salud denunció que, a pesar de que los patógenos de hongos siguen siendo una importante amenaza para la salud pública, se emplean muy pocos recursos en el desarrollo de medicamentos antifúngicos efectivos.
El informe, que involucró a más de 400 expertos en micología y una revisión de más de 6,000 trabajos de investigación, clasificó los tipos de patógenos fúngicos en tres grupos en función de su impacto potencial en la salud pública y el riesgo de resistencia a los medicamentos antimicóticos: prioridad crítica, alta y media.

En este sentido, el organismo de salud aconsejó a los gobiernos reforzar sus sistemas para monitorear hongos peligrosos y responder a las 19 variedades incluidas en la lista.
«Se alienta a los países a seguir un enfoque gradual, comenzando por el fortalecimiento de sus capacidades de vigilancia y laboratorio de enfermedades fúngicas, y asegurando el acceso equitativo a las terapias y diagnósticos de calidad existentes, a nivel mundial»; dijo el Dr. Haileyesus Getahun, director del Departamento de Coordinación Global de la Resistencia a los Antimicrobianos de la OMS.